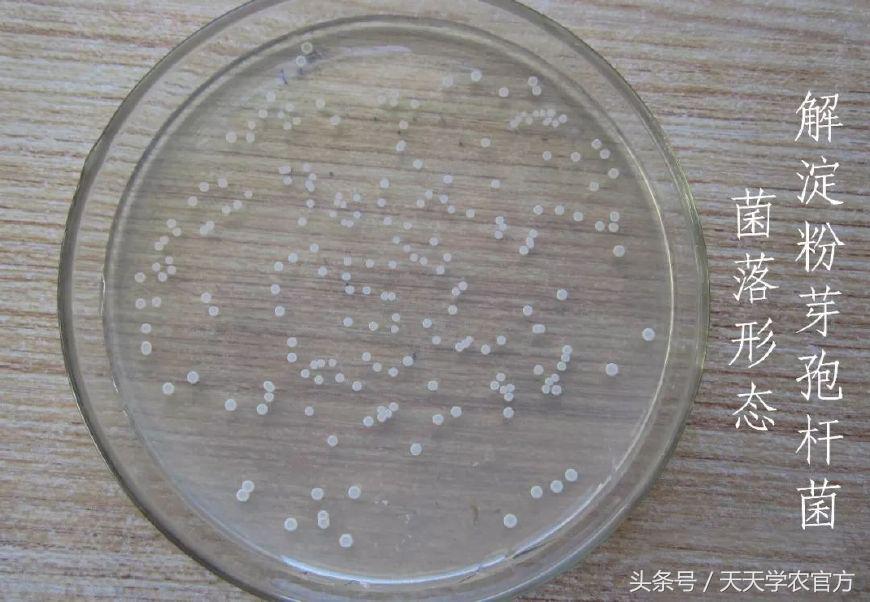
喷柑橘红蜘蛛喷什么农药好,生物叶面肥防治柑橘红蜘蛛

最近,有款药铺天盖地打广告,学农君关注的很多号基本都打过这个广告,甚至前几天学农君也“被打广告”了……
怎么被打广告呢?其实是因为学农君发现很久以前的一篇文章有了个留言,一点开就看到了“广告”。

所以,学农君出于好奇,搜索了一下这个药的信息,发现这个药的卖点主要有那么几点:
- 不是农药、农肥或者杀螨剂,但是可以杀红蜘蛛、锈蜘蛛,而且不会有抗性;
- 属于生物叶面肥,但是可以通过微生物杀虫螨,而且三分钟见效;
- 腐植酸、海藻酸、锌、锰、铁等等有益植物生长的元素它都能补充……

从广告上看,这真的是一款神药!甚至有那么一下子,学农君都觉得其他农药和肥料都可以不用,种柑只需要这一个产品就够了!
所以,学农君翻了一下群,发现已经有群友聊过这个产品,看得出来,大家对这产品也是存在着一些疑惑的。

那么,这个要到底有没有说的那么厉害呢?学农君查了一下这个产品的登记证号,确实有这款产品,活菌数、总养分和有机质也是吻合的。
需要注意的是,这款产品是以复合微生物肥料作为名称登记的,属于微生物肥,而且适用的作物为黄瓜。

所以,这款药有些地方存在着一些跟实际描述存在出入的地方,但总结起来,归根到底还是群聊天里面提到的是不是有“隐性成分”。
这款产品说三分钟能够杀螨杀虫,并把这个作用说成是“解淀粉芽孢杆菌、胶冻样类芽孢杆菌”能快速杀害螨虫,但是细菌真的那么高效吗?
一般而言,细菌在包装保存状态转移到溶液,就像我们经过长途运输,我们是需要一段时间恢复的,将粉剂进行稀释的时间是很难让它们活起来的,而喷了之后三分钟见效也更加难。
学农君查了一下细菌防治,发现汤普森多毛菌可以杀灭锈蜘蛛,但在外界条件合适的情况下菌体侵入锈蜘蛛至少还需要四个小时,把锈蜘蛛杀死则需要更多时间!这跟上面提到的这个产品的三分钟简直就是天壤之别。
这也是为什么在群聊天的截图里,有人怀疑这款药里面有隐性成分的原因,因为生物防治需要比较长时间的管理,所以如果要用这款药,学农君建议大家还是要慎重。
虫子到底怎么杀?
那么,如果不用这个肥,最近的虫子要怎么杀?又有哪些虫子需要注意?
1、虫害之王——木虱
到了秋季,黄龙病症状就会越来越明显,染病树就会出现相应症状。但这时候的树已经救不了了,唯一的解决办法就只有砍掉。

作为黄龙病唯一的田间传播媒介,嫩梢无疑是木虱最喜欢的叮的,只需要叮上3-4个小时,果树就只能等着被砍了。
所以杀除木虱一定要选择高效且速效的药物,药剂上首选菊脂类混配*碱烟**类,有效药物推荐:
- 20%甲氰菊酯+20%噻虫胺;
- 25%高效氯氰菊酯·噻虫嗪/噻虫胺;
- 甲氰菊酯/联苯菊酯+吡虫·吡丙醚。
2、遇梢伤梢的“鬼画符”
如果说木虱是黄龙病的“罪魁祸首”,那么溃疡病的“罪魁祸首”应该要算是潜叶蛾了!
现在沃柑、茂谷柑等品种扩种,溃疡病已经越来越泛滥,就像是以为果农朋友说的“其他病喷一喷药就没事,溃疡病却怎么都搞不好”。

而想要防住溃疡病,鬼画符潜叶蛾就一定要防好!其实,潜叶蛾不难防,只需注意以下三点:
- 防治潜叶蛾一定要趁早,嫩梢出来的2公分开始用药是效果最好的;如果等到10公分以后再用药就比较麻烦了;
- 用药的时候加入带内吸的药效果更好,比如我们用氯氰菊脂的时候,可以配吡虫啉进去,这样效果就更好;
- 现在是潜叶蛾重点防治,当出芽1-2公分的时候开始用药,间隔7-10天重新喷药。

潜叶蛾推荐用药:
- 氯氟菊酯·噻虫嗪/氯氟菊酯·噻虫胺;
- 20%甲氰菊酯+5%吡虫啉或25%噻虫嗪;
- 2.5%联苯菊脂+10%吡丙.吡虫啉;
- 也可用灭蝇胺等药防治。
3、繁殖小能手
除此之外,对嫩梢危害最严重的要数蚜虫了。蚜虫特别喜欢嫩梢,经常是成片出现,会造成叶面向背面卷曲。
症状较轻的会引起植株营养恶化、生长缓慢,并引起生长畸形、落叶、萎蔫,严重时甚至还会引起烟煤病,传播衰退病,使得新梢生长不良、幼果脱落,影响产量,造成树势衰弱。

所以,出现蚜虫一定要及时处理,不过由于蚜虫总在新梢、嫩梢上,用药要尽量避免使用会产生药害的,以保证新梢、嫩梢的正常发育。
推荐药剂有:5%啶虫脒;10%吡虫啉;25%噻虫嗪;20%噻虫胺等;如果有条件,还可以考虑混配药(如氯氟·噻虫嗪/胺;氯氟·啶虫脒等。)
4、“蛇蝎美人”
在常见的柑橘虫害里面,或许凤蝶是最好看的一种了,但好看并不影响它危害果子。现在是七月,正好是第一代凤蝶出现的时间,如果不能及时防控,就很容易被啃得遍体鳞伤。

对付凤蝶其实相对比较简单,注意统一放梢,结合防治潜叶蛾和蚜虫的药就可以比较有效控制了。
在这里,学农君再提醒一下大家,凤蝶的那些鳞翅目的亲戚(如斜纹夜蛾类、菜蛾、棉铃虫)也是很喜欢嫩梢的,对幼果危害也会十分严重,大家一定要注意防治。

5、其他
除了上面提到的这些,像红蜘蛛、锈壁虱、蓟马等虫害也应该要注意,不过这几种之前学农君已经提醒过很多次了,这里就不追溯了。
【特别声明】本文由天天学农学农君原创,转载请注明出处;部分图片素材源自网络,仅作为学习交流,如有侵权请联系删除!